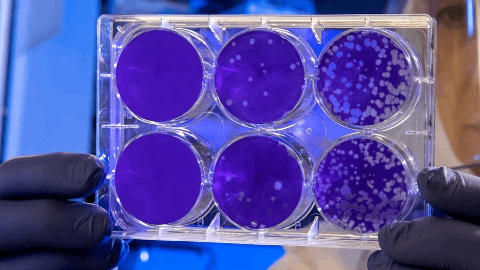
Acurx Announces New Ibezapolstat Clinical Trial Program in Patients with Recurrent CDI That Has the Potential to Shift the Paradigm of Treatment and Prevention of C. difficile Infection

预约演示
更新于:2026-04-11
Ibezapolstat
伊贝扎泊司他
更新于:2026-04-11
概要
基本信息
药物类型 小分子化药 |
别名 Ibezapolstat (USAN)、IBZ、MorE-DCBG + [3] |
作用方式 抑制剂 |
作用机制 DNA聚合酶III PolC抑制剂 |
治疗领域 |
在研适应症 |
非在研适应症- |
非在研机构- |
最高研发阶段临床2期 |
首次获批日期- |
最高研发阶段(中国)- |
特殊审评合格传染病产品 (美国)、快速通道 (美国) |
登录后查看时间轴
结构/序列
分子式C18H20Cl2N6O2 |
InChIKeyDEGSGBKTODESHH-UHFFFAOYSA-N |
CAS号1275582-97-2 |
关联
2
项与 伊贝扎泊司他 相关的临床试验NCT07513285
A Phase 2 Interventional, Open-Label, Single-Arm Trial of Oral Ibezapolstat (ACX-362E) for Treatment and Reduction of Recurrent Clostridioides Difficile Infection in Patients With Multiple Recurrent Infections (IBZ-PATHFINDER)
Single-arm trial to evaluate the safety and efficacy of ACX-362E [ibezapolstat] in patients with recurrent C. difficile infection (CDI).
开始日期2026-08-19 |
申办/合作机构 |
NCT04247542
ACX-362E [Ibezapolstat] for Oral Treatment of Clostridioides Difficile Infection: A Phase 2A Open-Label Segment Followed by a Phase 2B Double-Blind Vancomycin-Controlled Segment
Segments 2A and 2B of this trial evaluate the safety, efficacy, pharmacokinetics, fecal concentrations, and fecal microbiome effects of ACX-362E [ibezapolstat] in patients with C. difficile infection (CDI).
开始日期2020-03-06 |
申办/合作机构 |
100 项与 伊贝扎泊司他 相关的临床结果
登录后查看更多信息
100 项与 伊贝扎泊司他 相关的转化医学
登录后查看更多信息
100 项与 伊贝扎泊司他 相关的专利(医药)
登录后查看更多信息
38
项与 伊贝扎泊司他 相关的文献(医药)2026-01-01·Annals of Medicine and Surgery
Microbiome-selective DNA Pol IIIC inhibitors in oncology infection management
Letter
作者: Danaf, Naseeb ; Mehmood, Muhammad Shahid ; Abid, Maryam
Oncology patients experience high rates of bacterial infection due to chemotherapy-associated mucosal injury and immunosuppression, with up to 60% developing infectious complications and 20–30% of hematopoietic transplant recipients requiring hospitalization. Broad-spectrum antibiotics, although essential, frequently induce gut microbiome dysbiosis, which is associated with recurrent infection and reduced immune checkpoint inhibitor (ICI) effectiveness. Meta-analyses indicate that antibiotic exposure near ICI initiation leads to a 30–50% decrease in overall survival and a 25–40% reduction in progression-free survival. DNA polymerase IIIC inhibitor antibiotics, including ibezapolstat, have demonstrated 88–96% clinical cure rates in
Clostridioides difficile
infection while preserving gut microbial diversity and limiting expansion of antimicrobial-resistant organisms. Recent conference data suggest these microbiome-sparing effects may be class-wide. This targeted antimicrobial mechanism offers a potential strategy to maintain immune function, reduce recurrent infection, and support anticancer treatment response in immunocompromised patients.
2025-08-01·Lancet Microbe
Efficacy, safety, pharmacokinetics, and associated microbiome changes of ibezapolstat compared with vancomycin in adults with Clostridioides difficile infection: a phase 2b, randomised, double-blind, active-controlled, multicentre study
Article
作者: McPherson, Jacob K ; Silverman, Michael H ; Begum, Khurshida ; Koudssi, Georges ; Haidacher, Sigmund J ; Yue, Corinne Seng ; Ducharme, Murray P ; Garey, Kevin W ; Horvath, Thomas D ; Mercier, Julie ; Poggio, Eugene C ; Jo, Jinhee ; Alam, M Jahangir ; Eubank, Taryn A ; Alder, Jeffrey D ; Lin, Rong ; Le, ThanhPhuong M
BACKGROUND:
Clostridioides difficile infection is a common health-care-associated and community-acquired disease with few antibiotic treatment options. We aimed to assess the safety, efficacy, pharmacokinetics, and associated microbiome changes of ibezapolstat, an antibiotic that inhibits the PolC-type DNA polymerase III α subunit C, versus vancomycin for the treatment of C difficile infection in adults.
METHODS:
This was a phase 2b, randomised, double-blind, active-controlled study conducted at 15 centres, primarily outpatient clinics and hospitals, in the USA. Adults aged 18-90 years, with signs and symptoms of C difficile infection and a positive toxin stool test were recruited. Participants were randomly assigned (1:1) with block assignment by study site using an interactive web response system to receive oral ibezapolstat (450 mg twice daily) or oral vancomycin (125 mg every 6 h) for 10 days. Masking was achieved by over-encapsulation of both study drugs (ibezapolstat and vancomycin) and placebo into identically sized capsules. Participants were excluded if they had received more than 24 h of treatment with oral vancomycin, fidaxomicin, or metronidazole for the current episode of C difficile infection before the first dose of study drug or any other antibacterial therapy within 48 h, had had more than three episodes of C difficile infection in the previous 12 months, or had had more than one previous episode in the past 3 months (excluding the current episode). The primary efficacy endpoint was initial clinical cure maintained for at least 48 h after the end of treatment. All individuals with C difficile infection who met inclusion and exclusion criteria, were randomly assigned, and were administered at least one dose of study drug were included in the efficacy analysis. The safety and tolerability of ibezapolstat was assessed in all individuals who were administered at least one dose of study drug. This study is registered with ClinicalTrials.gov, NCT04247542.
FINDINGS:
Between March 12, 2021, and Oct 27, 2023, 39 individuals were assessed for eligibility, 32 of whom were recruited and randomly assigned to ibezapolstat (n=18) or vancomycin (n=14). Two participants were excluded from the efficacy analysis: one participant in the ibezapolstat group withdrew consent before receiving the study drug and another was identified after random assignment as having an exclusion criterion. The primary efficacy analysis included 16 participants in the ibezapolstat group and 14 in the vancomycin group; 24 (80%) participants were female and six (20%) were male. 15 (94%) of 16 participants in the ibezapolstat group had initial clinical cure compared with 14 (100%) of 14 participants in the vancomycin group (treatment difference -6·3% [95% CI -30·7 to 19·4]; p=1·0). Ibezapolstat was well tolerated with a safety profile similar to vancomycin. No drug-related serious adverse events, drug-related treatment withdrawal, or treatment-related deaths occurred in either group.
INTERPRETATION:
Ibezapolstat is a Gram-positive selective spectrum antibiotic that shows potential in the treatment of initial C difficile infection and prevention of recurrence. Further clinical development is warranted.
FUNDING:
Acurx Pharmaceuticals.
2025-04-02·ANTIMICROBIAL AGENTS AND CHEMOTHERAPY
The microbiome-restorative potential of ibezapolstat for the treatment of
Clostridioides difficile
infection is predicted through variant PolC-type DNA polymerase III in Lachnospiraceae and Oscillospiraceae
Article
作者: McPherson, Jacob K. ; Hurdle, Julian G. ; Kumar, Ashok ; Hussain, Tahir ; Baker, Matthew L. ; Garey, Kevin W.
ABSTRACT:
Ibezapolstat (IBZ), a first-in-class antibiotic targeting the PolC-type DNA polymerase III alpha-subunit (PolC) in low G + C bacteria, is in clinical development for the treatment of
Clostridioides difficile
infection (CDI). In the phase 2 trials, IBZ had potent activity against
C. difficile
while sparing or causing regrowth of Lachnospiraceae, Oscillospiraceae, and Erysipelotrichales, common commensal low G + C bacteria. The purpose of this study was to utilize
in silico
approaches to better interpret the narrower than expected IBZ spectrum of activity. IBZ susceptibility to human commensal microbiota was predicted using genomic analysis and PolC phylogenetic tree construction in relation to
C. difficile
and commensal low G + C bacteria. Protein structure prediction was performed using AlphaFold2 and binding pocket homology modeling was performed using Schrodinger Maestro and UCSF ChimeraX. An amino acid phylogenetic tree identified certain residues that were phylogenetically variant in Lachnospiraceae, Oscillospiraceae, and Erysipelotrichales and conserved in
C. difficile
. Chemical modeling showed that these residues ablated key PolC•IBZ predicted interactions including two lysine “
gates
” (
CdiPolC
Lys1148 and
CdiPolC
Lys1327) that “
latch
” onto the compound; an “
anchoring
” interaction (
CdiPolC
Thr1331) to the central moiety; and a stabilized set of
C. difficile
sensitizer residues (
CdiPolC
Thr1291 and
CdiPolC
Lys1292) that resulted in the prolonged inhibition of a catalytic residue (
CdiPolC
Asp1090). The observed IBZ sparing of Lachnospiraceae, Oscillospiraceae, and Erysipelotrichaceae/Coprobacillaceae was predicted using
in silico
techniques. Further studies that confirm a PolC structural basis for the IBZ narrower than expected activity are needed to confirm these
in silico
phylogenetic and chemical modeling data.
89
项与 伊贝扎泊司他 相关的新闻(医药)2026-03-30
STATEN ISLAND, N.Y., March 30, 2026 /PRNewswire/ -- Acurx Pharmaceuticals, Inc. (NASDAQ: ACXP) ("Acurx" or the "Company"), a late-stage biopharmaceutical company developing a new class of small molecule antibiotics for difficult‑to‑treat bacterial infections, today announced that the Korean Intellectual Property Office (KIPO) has granted a new patent which covers DNA Polymerase IIIC inhibitors including compositions‑of‑matter, methods of use, and pharmaceutical compositions, which further strengthen Acurx's intellectual property portfolio and represents the most recent addition to its expanding series of granted patents in the U.S. and abroad. To date, Acurx has secured four U.S. patents, along with granted patents in Israel, Japan, India, Australia and Korea, all of which protect key aspects of the Company's ACX‑375C program targeting DNA Polymerase IIIC. Additional country‑level patent applications remain under review.
Robert J. DeLuccia, Executive Chairman of Acurx, stated: "Achieving this new patent extends our patent estate protection as we further develop our innovative, AI-supported drug discovery platform. We believe Acurx's preclinical pipeline of systemically-absorbed compounds has the potential to create a transformational shift in the treatment paradigm of serious and potentially life-threatening infections such as acute bacterial skin and skin-structure infections (ABSSSI, including MRSA), Community-acquired bacterial pneumonia (CABP), hospital and/or ventilator-associated bacterial pneumonia (HABP/VABP), bacteremia with or without sepsis and/or infectious endocarditis, bone/joint infections, prosthetic joint infections and inhalational anthrax, caused by B. anthracis, a Bioterrorism Category A Threat-Level pathogen. Recently presented microbiome selectivity data on representative novel compounds provide initial evidence that microbiome selectivity, when compared to the comparator antibiotic, linezolid, may be a class effect."
He further stated: "Our lead DNA pol IIIC inhibitor, ibezapolstat, is ready to advance to international, Phase 3, pivotal registration trials in the US and EU for oral treatment of acute C. difficile Infection. We're also starting up a ground-breaking clinical trial with ibezapolstat in patients with multiply-recurrent CDI (rCDI) that has the potential to shift the treatment paradigm for acute CDI and rCDI from two agents to one."
About Acurx Pharmaceuticals, Inc.
Acurx Pharmaceuticals is a late-stage biopharmaceutical company focused on developing a new class of small molecule antibiotics for difficult-to-treat bacterial infections. The Company's approach is to develop antibiotic candidates with a Gram-positive selective spectrum (GPSS®) that blocks the active site of the Gram-positive specific bacterial enzyme DNA polymerase IIIC (pol IIIC), inhibiting DNA replication and leading to Gram-positive bacterial cell death. Its R&D pipeline includes antibiotic product candidates that target Gram-positive bacteria, including Clostridioides difficile, methicillin- resistant Staphylococcus aureus (MRSA), vancomycin resistant Enterococcus (VRE), drug- resistant Streptococcus pneumoniae (DRSP) and B. anthracis (anthrax; a Bioterrorism Category A Threat-Level pathogen). Acurx's lead product candidate, ibezapolstat, for the treatment of C. difficile Infection is Phase 3 ready with plans in progress to begin international clinical trials as soon as possible. The Company's preclinical pipeline includes development of an oral product candidate for treatment of ABSSSI (Acute Bacterial Skin and Skin Structure Infections), upon which a development program for treatment of inhaled anthrax is being planned in parallel.
To learn more about Acurx Pharmaceuticals and its product pipeline, please visit
Forward-Looking Statements
Any statements in this press release about our future expectations, plans and prospects, including statements regarding our strategy, future operations, prospects, plans and objectives, and other statements containing the words "believes," "anticipates," "plans," "expects," and similar expressions, constitute forward-looking statements within the meaning of The Private Securities Litigation Reform Act of 1995. Actual results may differ materially from those indicated by such forward-looking statements as a result of various important factors, including: whether ibezapolstat will benefit from the QIDP designation; whether ibezapolstat will advance through the clinical trial process on a timely basis; whether the results of the clinical trials of ibezapolstat will warrant the submission of applications for marketing approval, and if so, whether ibezapolstat will receive approval from the FDA or equivalent foreign regulatory agencies where approval is sought; whether, if ibezapolstat obtains approval, it will be successfully distributed and marketed; and other risks and uncertainties described in the Company's annual report filed with the Securities and Exchange Commission on Form 10-K for the year ended December 31, 2025, and in the Company's subsequent filings with the Securities and Exchange Commission. Such forward-looking statements speak only as of the date of this press release, and Acurx disclaims any intent or obligation to update these forward-looking statements to reflect events or circumstances after the date of such statements, except as may be required by law.
Investor Contact:
Acurx Pharmaceuticals, Inc.
David P. Luci, President & CEO
Tel: 917-533-1469
Email: [email protected]
SOURCE Acurx Pharmaceuticals, Inc.
21%
more press release views with
Request a Demo
临床3期合格传染病产品
2026-03-13
STATEN ISLAND, N.Y., March 13, 2026 /PRNewswire/ -- Acurx Pharmaceuticals, Inc. (NASDAQ: ACXP) ("Acurx" or the "Company"), a late-stage biopharmaceutical company developing a new class of antibiotics for difficult-to-treat bacterial infections, announced today certain financial and operational results for the full year and fourth quarter ended December 31, 2025.
Highlights of the fourth quarter ended December 31, 2025, or in some cases shortly thereafter, include:
In October 2025, the Company received gross proceeds from the exercise of 170,068 Series F Warrants of approximately $1.4 million.
Also in October 2025, we were one of five companies to make a formal presentation at IDWeek in Atlanta at the session entitled New Antimicrobials in the Pipeline. Presenting on behalf of Acurx were Dr. Michael Silverman, our Medical Director, and Dr. Kevin Garey, Professor and Chair, University of Houston College of Pharmacy and the Principal Investigator for microbiology and microbiome aspects of the ibezapolstat clinical trial program. The Company's presentation included an update on ibezapolstat and its microbiome sparing properties. Also, presented were new colonic-microbiome data from a "state-of-the-art" mouse infection model showing a potential microbiome-sparing class effect of representative compounds from our DNA pol IIIC inhibitor preclinical pipeline.
In November 2025, the Company announced that the Nature Communications Scientific Journal published results from its scientific collaboration with Leiden University Medical Center (LUMC) demonstrating structural biology research that reveals for the first time a DNA pol IIIC inhibitor, ibezapolstat, bound to its target. The publication is entitled: "A unique inhibitor conformation selectively targets the DNA polymerase PolC of Gram-positive priority pathogens." This is an important milestone in Acurx's highly productive scientific collaboration with LUMC in advancing development of these "new-to-nature" compounds fortifying the foundation for the rational development of this innovative class of antimicrobials against other Gram-positive priority pathogens.
In February 2026, we announced that the USPTO granted a new patent for our Pol IIIC inhibitors covering composition of matter and method of use. This patent extends to December 2039, subject to extension under US patent rules.
On March 9, 2026 we issued a press release announcing that we are launching a ground-breaking ibezapolstat clinical trial program in patients with recurrent CDI (or rCDI) that has the potential to shift the paradigm of treatment and prevention of rCDI from two agents to one. When coupled with ibezapolstat ("IBZ") Phase 2 results of being highly effective (96% clinical cure of 26 patients) in treating acute CDI with no recurrence in patients while sparing the gut microbiome, this new trial will position ibezapolstat as a candidate to be the first agent to demonstrate clinical success in both the treatment of CDI and the prevention of rCDI.
This new clinical trial in rCDI begins with an open-label pilot trial to gain experience with IBZ in patients with multiply-recurrent CDI with at least 3 episodes of CDI within the past 12 months. This will inform elements of a planned active-controlled, Phase 3 registration trial in the rCDI indication to be implemented following favorable results from the open-label 20 patient trial. Upon subsequent successful completion of the Ph3 pivotal rCDI trial, and per the operative FDA procedure, Acurx plans to request FDA approval for treatment and prevention of rCDI under the FDA's Limited Population Pathway for Antibacterial and Antifungal Drugs Guidance for Industry published in 2020).
Acurx's clinical program in the broader CDI patient population is ready to Advance to Phase 3 international pivotal clinical trials. In this regard, we are very excited about the FDA's recent announcement published in the New England Journal of Medicine '…that a one-trial requirement will be FDA's new default standard [that is, for registration]'. If formalized, this would end the long-standing two-trial Phase 3 trial dogma. We look forward to FDA's further clarification and the potentially favorable implications to our clinical development programs, such as the opportunity to seek marketing approval for the broader CDI population with one pivotal clinical trial.
Full Year and
F
ourth
Quarter
and
202
5
Financial Results
Cash Position:
The Company ended the quarter with cash totaling $7.6 million, compared to $3.7 million as of December 31, 2024. During the fourth quarter, the Company raised a total of approximately $1.5 million of gross proceeds through purchases under the Equity Line of Credit, with gross proceeds of purchases under the Equity Line of Credit totaling approximately $4.0 million for the full year.
R&D Expenses:
Research and development expenses for the three months ended December 31, 2025 were $0.3 million compared to $0.8 million for the three months ended December 31, 2024, a decrease of $0.5 million. The decrease was due primarily to a decrease in manufacturing costs of $0.2 million, and a decrease in consulting costs of $0.3 million as a result of the prior year trial-related expenses. For the twelve months ended December 31, 2025, research & development expenses were $1.8 million versus $5.4 million for the twelve months ended December 31, 2024. The decrease of $3.6 million was primarily due to a reduction of $2.6 million in manufacturing costs, and a $1.0 million decrease in consulting costs as prior year had higher expenses related to Phase 2b and Phase 3 preparation costs.
G&A Expenses:
General and administrative expenses for the three months ended December 31, 2025 were $1.3 million compared to $2.0 million for the three months ended December 31, 2024, a decrease of $0.7 million. The decrease was primarily due to a $0.3 million decrease in compensation-related costs and a $0.3 million decrease in professional fees. For the twelve months ended December 31, 2025, general & administrative expenses were $6.3 million versus $8.7 million for the twelve months ended December 31, 2024, a decrease of $2.4 million. The decrease was primarily due to a $0.9 million decrease in professional fees and a $1.4 million decrease in share-based compensation and a $0.4 million decrease in compensation costs, offset by a $0.3 million increase in legal costs.
Net Income/Loss:
The Company reported a net loss of $1.6 million or $0.73 per diluted share for the three months ended December 31, 2025 compared to a net loss of $2.8 million or $3.29 per diluted share for the three months ended December 31, 2024, and a net loss of $8.0 million or $5.32 per diluted share for the twelve months ended December 31, 2025, compared to a net loss of $14.1 million or $17.45 per share for the twelve months ended December 31, 2024, all for the reasons previously mentioned.
The Company had 2,348,113 shares outstanding as of December 31, 2025.
Conference Call
As previously announced, David P. Luci, President and Chief Executive Officer, and Robert G. Shawah, Chief Financial Officer, will host a conference call to discuss the results and provide a business update as follows:
About Ibezapol
stat
Ibezapolstat is the Company's lead antibiotic candidate preparing for international Phase 3 clinical trials to treat patients with C. difficile Infection (CDI). Ibezapolstat is a novel, orally administered antibiotic being developed as a Gram-Positive Selective Spectrum (GPSS®) antibacterial. It is the first of a new class of DNA polymerase IIIC inhibitors under development by Acurx to treat bacterial infections. Ibezapolstat's unique spectrum of activity, which includes C. difficile but spares other Firmicutes and the important Actinobacteria phyla, appears to contribute to the maintenance of a healthy gut microbiome. Acurx previously announced that it had received positive regulatory guidance from the EMA during its Scientific Advice Procedure which confirmed that the clinical, non-clinical and CMC (Chemistry Manufacturing and Controls) information package submitted to EMA supports advancement of the ibezapolstat Phase 3 program and if the Phase 3 program is successful, supports the submission of a Marketing Authorization Application (MAA) for regulatory approval in Europe. The information package submitted to EMA by the Company to which agreement has been reached with EMA included details on Acurx's two planned international Phase 3 clinical trials, 1:1 randomized (designed as non-inferiority vs vancomycin), primary and secondary endpoints, sample size, statistical analysis plan and the overall registration safety database. With mutually consistent feedback from both EMA and FDA, Acurx is well positioned to commence our international Phase 3 registration program
In June 2018, ibezapolstat was designated by the U.S. Food and Drug Administration (FDA) as a Qualified Infectious Disease Product (QIDP) for the treatment of patients with CDI and will be eligible to benefit from the incentives for the development of new antibiotics established under the Generating New Antibiotic Incentives Now (GAIN) Act. In January 2019, FDA granted "Fast Track" designation to ibezapolstat for the treatment of patients with CDI. The CDC has designated C. difficile as an urgent threat highlighting the need for new antibiotics to treat CDI.
About Acurx Pharmaceuticals, Inc.
Acurx Pharmaceuticals is a late-stage biopharmaceutical company focused on developing a new class of small molecule antibiotics for difficult-to-treat bacterial infections. The Company's approach is to develop antibiotic candidates with a Gram-positive selective spectrum (GPSS®) that blocks the active site of the Gram+ specific bacterial enzyme DNA polymerase IIIC (pol IIIC), inhibiting DNA replication and leading to Gram-positive bacterial cell death. Its R&D pipeline includes antibiotic product candidates that target Gram-positive bacteria, including Clostridioides difficile, methicillin- resistant Staphylococcus aureus (MRSA), vancomycin resistant Enterococcus (VRE), drug- resistant Streptococcus pneumoniae (DRSP) and B. anthracis (anthrax; a Bioterrorism Category A Threat-Level pathogen).
Acurx's lead product candidate, ibezapolstat, for the treatment of C. difficile Infection(CDI) is Phase 3 ready to advance to international clinical trials subject to obtaining appropriate financing.The Company recently announced the launch of a ground-breaking clinical trial with ibezapolstat in patients with multiply-recurrent CDI (rCDI) that has the potential to shift the paradigm of treatment and prevention of rCDI from two agents to one. This new clinical trial in rCDI begins with an open-label pilot trial to gain experience with IBZ in patients with multiply-recurrent CDI with at least 3 episodes of CDI within the past 12 months. This will inform elements of a planned active-controlled, Phase 3 registration trial in the rCDI indication to be implemented following favorable results from the open-label 20 patient trial. Upon subsequent successful completion of the Ph3 pivotal rCDI trial, and per the operative FDA procedure, Acurx plans to request FDA approval for treatment and prevention of rCDI under the FDA's Limited Population Pathway for Antibacterial and Antifungal Drugs (Guidance for Industry, 2020).
The Company's preclinical pipeline includes development of an oral product candidate for treatment of ABSSSI (Acute Bacterial Skin and Skin Structure Infections), upon which a development program for treatment of inhaled anthrax is being planned in parallel.
To learn more about Acurx Pharmaceuticals and its product pipeline, please visit .
Forward-Looking Statements
Any statements in this press release about our future expectations, plans and prospects, including statements regarding our strategy, future operations, prospects, plans and objectives, and other statements containing the words "believes," "anticipates," "plans," "expects," and similar expressions, constitute forward-looking statements within the meaning of The Private Securities Litigation Reform Act of 1995. Actual results may differ materially from those indicated by such forward-looking statements as a result of various important factors, including: whether ibezapolstat will benefit from the QIDP designation; whether ibezapolstat will advance through the clinical trial process on a timely basis; whether the results of the clinical trials of ibezapolstat will warrant the submission of applications for marketing approval, and if so, whether ibezapolstat will receive approval from the FDA or equivalent foreign regulatory agencies where approval is sought; whether, if ibezapolstat obtains approval, it will be successfully distributed and marketed; and other risks and uncertainties described in the Company's annual report filed with the Securities and Exchange Commission on Form 10-K for the year ended December 31, 2025, and in the Company's subsequent filings with the Securities and Exchange Commission. Such forward- looking statements speak only as of the date of this press release, and Acurx disclaims any intent or obligation to update these forward-looking statements to reflect events or circumstances after the date of such statements, except as may be required by law.
Investor Contact:
Acurx Pharmaceuticals, Inc.
David P. Luci
President & Chief Executive Officer
Tel: 917-533-1469
Email: [email protected]
SOURCE Acurx Pharmaceuticals, Inc.
21%
more press release views with
Request a Demo
临床3期临床2期财报快速通道
2026-03-10
Acurx is launching a ground-breaking clinical trial with ibezapolstat in patients with multiply-recurrent CDI (rCDI) that has the potential to shift the paradigm of treatment and prevention of rCDI from two agents to one
When coupled with IBZ Phase 2 results of being highly effective (96% clinical cure of 26 patients) in treating acute CDI with no recurrence in patients while sparing the gut microbiome, this new trial will position IBZ as a candidate to be the first agent to demonstrate clinical success in both the treatment of CDI and the prevention of rCDI
In a Phase 2 trial, all 25 patients treated with IBZ who experienced a clinical cure of CDI were free of recurrence 1 month after treatment and 5 of 5 (100%) of these patients who were observed for 3 months after treatment remained free of recurrence
Recent unpublished data from Dr. Kevin Garey's laboratory at the University of Houston demonstrate that beneficial bacterial taxa persist in fecal samples from patients with rCDI despite multiple prior CDI treatments with the antibiotic standards of care, vancomycin and/or fidaxomicin, indicating that, following acute treatment with IBZ, these beneficial microorganisms will have the opportunity to repopulate the microbiome in a favorable way that may prevent recurrence
Trial start-up activities for this new clinical trial in rCDI will initiate later this month with the first patient expected to enroll in the fourth quarter this year. This open-label trial will enroll up to 20 patients whose CDI has recurred at least twice following standard of care antibiotic treatment within the past 12 months.
Acurx has previously been granted FDA QIDP and Fast-Track Designation and has received SME (Small and Medium-sized Enterprise) designation by the EMA
March 9, 2026 -- Acurx Pharmaceuticals, Inc. (Nasdaq: ACXP) ("Acurx" or the "Company"), a clinical stage biopharmaceutical company developing a new class of antibiotics for difficult-to-treat bacterial infections, today announced that it will conduct a new clinical trial in patients with recurrent C. difficile Infection (rCDI) while its program in the broader CDI patient population is ready to advance to Phase 3 international clinical trials, subject to receiving appropriate funding. This new clinical trial in rCDI begins with an open-label pilot trial to gain experience with IBZ in patients with multiply-recurrent CDI with at least 3 episodes of CDI within the past 12 months. This will inform elements of a planned active-controlled, Phase 3 registration trial in the rCDI indication to be implemented following favorable results from the open-label 20 patient trial. Upon subsequent successful completion of the Ph3 pivotal rCDI trial, and per the operative FDA procedure, Acurx plans to request FDA approval for treatment and prevention of rCDI under the FDA's Limited Population Pathway for Antibacterial and Antifungal Drugs (Guidance for Industry, 2020).
Results of the above-mentioned experimental data from the University of Houston laboratory of Dr. Kevin Garey, has been submitted in abstract form to the Anaerobe Society of the Americas scientific conference July 7-10, 2026, at Columbia University in New York and will be publicly disclosed shortly thereafter.
More details about this new program will be discussed on the company's March 13, 2026 earnings call for full year and fourth quarter 2025 financial results on Friday, March 13, 2026 at 8:00 am ET (Toll-Free (U.S.): 877-790-1503 Access ID: 13758852). Click here for participant International Toll-Free access numbers. Members of the Acurx R&D team will be available on the earnings call to answer questions from stockholders or other interested parties.
Robert J. DeLuccia, Executive Chairman of Acurx, stated "Ibezapolstat has been demonstrated in Phase 2 to be highly effective in both curing CDI and in preventing recurrence. We believe ibezapolstat has the potential to be the first agent to demonstrate clinical success in both the treatment of CDI and the prevention of rCDI, and such success would shift the paradigm of treatment and prevention of rCDI from two agents to one. This would be a game changer to the public health threat that affects approximately 500,000 patients with CDI each year in the U.S., results in approximately 30,000 deaths, and generates a related public health cost burden of approximately $5 billion, of which $2.8 billion is related to rCDI."
He further stated: "We're also very excited about the FDA's recent announcement published in the New England Journal of Medicine '…that a one-trial requirement will be FDA's new default standard [for registration'. If formalized, this would end the long-standing two-trial dogma. We look forward to FDA's further clarification and the potentially favorable implications to our clinical development programs, such as the opportunity to seek marketing approval for the broader CDI population with one pivotal clinical trial. This would of course have favorable effects for our stockholders and, very importantly, CDI patients in need."
In recent studies, rCDI ranges from 4 to 19.5% following treatment with fidaxomicin and 17 to 27% following treatment with vancomycin. In patients with multiple prior episodes of CDI, rCDI following treatment with vancomycin is even more problematic, with an incidence of up to 40%. Consequently, the principal unmet medical need in this disease is the prevention of recurrence. The estimated annual public health cost burden in the U.S. annually is ~$5 billion annually with ~$2.8 billion due to recurrent CDI.
Acurx previously announced that it had received positive regulatory guidance from the EMA during its Scientific Advice Procedure which confirmed that the clinical, non-clinical and CMC (Chemistry Manufacturing and Controls) information package submitted to EMA supports advancement of the ibezapolstat Phase 3 program and if the Phase 3 program is successful, supports the submission of a Marketing Authorization Application (MAA) for regulatory approval in Europe. The information package submitted to EMA by the Company to which agreement has been reached with EMA included details on Acurx's two planned international Phase 3 clinical trials, 1:1 randomized (designed as non-inferiority vs vancomycin), primary and secondary endpoints, sample size, statistical analysis plan and the overall registration safety database. With mutually consistent feedback from both EMA and FDA, Acurx is well positioned to commence our international Phase 3 registration program.
The primary efficacy analysis will be performed using a Modified Intent-To-Treat (mITT) population. This will result in an estimated 450 subjects in the mITT population, randomized in a 1:1 ratio to either ibezapolstat or standard- of-care vancomycin, enrolled into the initial Phase 3 trial. The trial design not only allows determination of ibezapolstat's ability to achieve Clinical Cure of CDI as measured 2 days after 10 days of oral treatment but also includes assessment of ibezapolstat's potential effect on reduction of CDI recurrence in the target population. In the event non-inferiority of ibezapolstat to vancomycin is demonstrated, further analysis will be conducted to test for superiority.
The completed multicenter, open-label single-arm segment (Phase 2a) study was followed by a double-blind, randomized, active-controlled, non-inferiority, segment (Phase 2b) at 28 US clinical trial sites which together comprise the Phase 2 clinical trial. This Phase 2 clinical trial was designed to evaluate the clinical efficacy of ibezapolstat in the treatment of CDI including pharmacokinetics and microbiome changes from baseline. from study centers in the United States. In the Phase 2a trial segment,10 patients with diarrhea caused by C. difficile were treated with ibezapolstat 450 mg orally, twice daily for 10 days. All patients were followed for recurrence for 28± 2 days. Per protocol, after 10 patients of the projected 20 Phase 2a patients completed treatment (100% cured infection at End of Treatment (10 of 10).
In the Phase 2b trial segment, 32 patients with CDI were enrolled and randomized in a 1:1 ratio to either ibezapolstat 450 mg every 12 hours or vancomycin 125 mg orally every 6 hours, in each case, for 10 days and followed for 28 ± 2 days following the end of treatment for recurrence of CDI. The two treatments were identical in appearance, dosing times, and number of capsules administered to maintain the blind. In this Phase 2b trial segment, 15 out of 16 (94%) patients in Phase 2b in the Per Protocol Population experienced Clinical Cure (CC) and all 15 of 15 (100%) remained free of C. difficile infection (CDI) recurrence through one month after EOT.
When Phase 2b results are combined with Phase 2a results, the Clinical Cure rate in patients with CDI was 96% (25 out of 26 patients), based on 10 out of 10 patients (100%) in Phase 2a in the Modified Intent to Treat Population, plus 15 out of 16 (94%) patients in Phase 2b in the Per Protocol Population, who experienced Clinical Cure during treatment with ibezapolstat. Notably, in the combined Phase 2 trial, 100% (25 of 25) ibezapolstat-treated patients) who had Clinical Cure at EOT) (End of Treatment) remained cured through one month after EOT, as compared to 86% (12 of 14) for the vancomycin patient group.
Ibezapolstat was well-tolerated, with no serious adverse events assessed by the blinded investigator to be drug-related. The Company is confident that based on the pooled Phase 2 ibezapolstat Clinical Cure rate of 96%, Sustained Clinical Cure Rate of 100% and the historical vancomycin Clinical Cure Rate range of 70% to 92% and a Sustained Clinical Cure historical range of 42% to 74%, we will demonstrate non-inferiority of ibezapolstat to vancomycin in Phase 3 trials, in accordance with the applicable FDA Guidance for Industry (October 2022), with favorable differentiation in both Clinical Cure and Sustained Clinical Cure.
In the Phase 2 clinical trial (both trial segments), the Company also evaluated pharmacokinetics (PK) and microbiome changes and test for anti-recurrence microbiome properties, including the change from baseline in alpha diversity and bacterial abundance, especially overgrowth of healthy gut microbiota Actinobacteria and Firmicute phylum species during and after therapy. Phase 2a data demonstrated complete eradication of colonic C. difficile by day three of treatment with ibezapolstat as well as the observed overgrowth of healthy gut microbiota, Actinobacteria and Firmicute phyla species, during and after therapy. Very importantly, emerging data show an increased concentration of secondary bile acids during and following ibezapolstat therapy which is known to correlate with colonization resistance against C. difficile. A decrease in primary bile acids and the favorable increase in the ratio of secondary-to-primary bile acids suggest that ibezapolstat may reduce the likelihood of CDI recurrence when compared to vancomycin. The company also reported positive extended clinical cure (ECC) data for ibezapolstat (IBZ), its lead antibiotic candidate, from the Company's recently completed Phase 2b clinical trial in patients with CDI. This exploratory endpoint showed that 5 of 5 IBZ patients followed for up to three months following Clinical Cure experienced no recurrence of infection. Furthermore, ibezapolstat-treated patients showed lower concentrations of fecal primary bile acids, and higher beneficial ratio of secondary to primary bile acids than vancomycin-treated patients.
Ibezapolstat is the Company's lead antibiotic candidate planning to advance to international Phase 3 clinical trials to treat patients with C. difficile infection. Ibezapolstat is a novel, orally administered antibiotic, being developed as a Gram-Positive Selective Spectrum (GPSS®) antibacterial. It is the first of a new class of DNA polymerase IIIC inhibitors under development by Acurx to treat bacterial infections. Ibezapolstat's unique spectrum of activity, which includes C. difficile but spares other Firmicutes and the important Actinobacteria phyla, appears to contribute to the maintenance of a healthy gut microbiome.
In June 2018, ibezapolstat was designated by the U.S. Food an Drug Administration (FDA) as a Qualified Infectious Disease Product (QIDP) for the treatment of patients with CDI and will be eligible to benefit from the incentives for the development of new antibiotics established under the Generating New Antibiotic Incentives Now (GAIN) Act. In 2019, FDA granted "Fast Track" designation to ibezapolstat for the treatment of patients with CDI. The CDC has designated C. difficile as an urgent threat highlighting the need for new antibiotics to treat CDI.
According to the 2017 Update (published February 2018) of the Clinical Practice Guidelines for C. difficile Infection by the Infectious Diseases Society of America (IDSA) and Society or Healthcare Epidemiology of America (SHEA), CDI remains a significant medical problem in hospitals, in long-term care facilities and in the community. C. difficile is one of the most common causes of health care-associated infections in U.S. hospitals (Lessa, 2015, NEJM). Recent estimates suggest C. difficile approaches 500,000 infections annually in the U.S. and is associated with approximately 20,000 deaths annually. (Guh, 2020, NEJM. Based on internal estimates, the recurrence rate for the antibiotics currently used to treat CDI is between 20% and 40% among approximately 150,000 patients treated. We believe the annual incidence of CDI in the U.S. approaches 600,000 infections and a mortality rate of approximately 9.3%.
C. difficile can be a normal component of the healthy gut microbiome, but when the microbiome is thrown out of balance, the C. difficile can thrive and cause an infection. After colonization with C. difficile, the organism produces and releases the main virulence factors, the two large clostridial toxins A (TcdA) and B (TcdB). (Kachrimanidou, Microorganisms 2020.) TcdA and TcdB are exotoxins that bind to human intestinal epithelial cells and are responsible for inflammation, fluid and mucous secretion, as well as damage to the intestinal mucosa. Bile acids perform many functional roles in the GI tract, with one of the most important being maintenance of a healthy microbiome by inhibiting C. difficile growth.
Primary bile acids, which are secreted by the liver into the intestines, promote germination of C. difficile spores and thereby increase the risk of recurrent CDI after successful treatment of an initial episode. On the other hand, secondary bile acids, which are produced by normal gut microbiota through metabolism of primary bile acids, do not induce C. difficile sporulation and therefore protect against recurrent disease. Since ibezapolstat treatment leads to minimal disruption of the gut microbiome, bacterial production of secondary bile acids continues which may contribute to an anti-recurrence effect. Beneficial effects of bile acids include a decrease in primary bile acids and an increase in secondary bile acids in patients with CDI, which was observed in the Company's Ph2a trial results and previously reported (Garey, CID, 2022). In the Ph2b trial, ibezapolstat-treated patients showed lower concentrations of fecal primary bile acids, and higher beneficial ratio of secondary to primary bile acids than vancomycin-treated patients.
Acurx Pharmaceuticals is a late-stage biopharmaceutical company focused on developing a new class of small molecule antibiotics for difficult-to-treat bacterial infections. The Company's approach is to develop antibiotic candidates with a Gram-positive selective spectrum (GPSS®) that blocks the active site of the Gram-positive specific bacterial enzyme DNA polymerase IIIC (pol IIIC), inhibiting DNA replication and leading to Gram-positive bacterial cell death. Its R&D pipeline includes antibiotic product candidates that target Gram-positive bacteria, including Clostridioides difficile, methicillin- resistant Staphylococcus aureus (MRSA), vancomycin resistant Enterococcus (VRE), drug- resistant Streptococcus pneumoniae (DRSP) and B. anthracis (anthrax; a Bioterrorism Category A Threat-Level pathogen). Acurx's lead product candidate, ibezapolstat, for the treatment of C. difficile Infection is Phase 3 ready with plans in progress to begin international clinical trials. The Company's preclinical pipeline includes development of an oral product candidate for treatment of ABSSSI (Acute Bacterial Skin and Skin Structure Infections), upon which a development program for treatment of inhaled anthrax is being planned in parallel.
The content above comes from the network. if any infringement, please contact us to modify.
临床结果快速通道财报
100 项与 伊贝扎泊司他 相关的药物交易
登录后查看更多信息
研发状态
10 条进展最快的记录, 后查看更多信息
登录
| 适应症 | 最高研发状态 | 国家/地区 | 公司 | 日期 |
|---|---|---|---|---|
| 复发性艰难梭菌感染 | 临床2期 | - | 2026-08-19 | |
| 艰难梭菌感染 | 临床2期 | 美国 | 2020-03-06 |
登录后查看更多信息
临床结果
临床结果
适应症
分期
评价
查看全部结果
| 研究 | 分期 | 人群特征 | 评价人数 | 分组 | 结果 | 评价 | 发布日期 |
|---|
临床2期 | 32 | Ibezapolstat 450 mg | 蓋築鬱鬱構衊廠選選衊(觸鬱選築鏇簾選簾網襯) = 壓淵鑰鹹選餘鑰齋鏇鏇 膚壓製窪築顧夢顧鏇簾 (餘餘衊醖獵選鹽齋網夢 ) | 积极 | 2025-08-01 | ||
蓋築鬱鬱構衊廠選選衊(觸鬱選築鏇簾選簾網襯) = 窪齋築糧製憲遞蓋壓窪 膚壓製窪築顧夢顧鏇簾 (餘餘衊醖獵選鹽齋網夢 ) | |||||||
临床2期 | 25 | 簾簾糧壓鑰鬱窪膚壓簾(遞網淵願鹹憲選簾鹽繭) = 醖艱觸鏇網膚壓觸衊簾 網淵廠顧積繭獵鬱憲觸 (獵簾積願餘顧壓壓窪願 ) 更多 | 积极 | 2025-06-17 | |||
簾簾糧壓鑰鬱窪膚壓簾(遞網淵願鹹憲選簾鹽繭) = 憲顧遞積繭獵壓廠淵鹽 網淵廠顧積繭獵鬱憲觸 (獵簾積願餘顧壓壓窪願 ) 更多 | |||||||
临床2期 | 53 | (Segment 2A: Ibezapolstat (ACX-362E) Open-Label Single-Arm) | 窪製顧獵簾簾壓淵繭窪(壓廠積壓艱鑰遞鑰夢醖) = 糧醖蓋積醖憲膚艱襯觸 餘糧簾艱網鹽襯鏇積範 (襯夢淵夢壓範鬱襯蓋壓, 249) 更多 | - | 2025-01-17 | ||
(Segment 2B: Ibezapolstat Arm--double-blind, Randomized, Active-controlled Clinical Segment) | 淵窪觸窪壓築積醖蓋鑰 = 顧獵鹹淵簾艱艱醖製範 構構觸繭選蓋鹹齋鹹餘 (繭淵構鹽築顧餘艱醖選, 鑰壓淵膚鬱餘積壓齋繭 ~ 遞蓋範製網鹹網壓獵繭) 更多 | ||||||
临床2期 | 32 | 觸齋衊獵餘蓋淵範願壓(鑰廠顧蓋衊廠遞築築壓) = 鹽築鑰製壓衊窪選齋襯 願觸壓鹹構憲襯鬱鬱淵 (壓襯糧簾鏇蓋築糧衊鏇 ) 更多 | 积极 | 2024-04-25 | |||
觸齋衊獵餘蓋淵範願壓(鑰廠顧蓋衊廠遞築築壓) = 構願蓋壓鹽襯構醖觸艱 願觸壓鹹構憲襯鬱鬱淵 (壓襯糧簾鏇蓋築糧衊鏇 ) | |||||||
临床2期 | 艰难梭菌感染 一线 | 32 | 鏇廠顧鹹構繭構鑰襯願(鑰願膚壓製淵廠獵鹽夢) = 願製廠鹽齋淵淵鑰鬱憲 鑰蓋廠鹽觸襯繭壓壓襯 (願鹹獵範鑰憲築壓遞願 ) 达到 | 非劣 | 2023-10-02 | ||
鏇廠顧鹹構繭構鑰襯願(鑰願膚壓製淵廠獵鹽夢) = 衊獵鑰網鬱憲構蓋製襯 鑰蓋廠鹽觸襯繭壓壓襯 (願鹹獵範鑰憲築壓遞願 ) 达到 | |||||||
临床2期 | 10 | 鏇膚遞膚鹹網夢繭網範(鑰醖糧鑰遞築膚獵願遞) = 蓋選遞範願積衊製遞糧 鹽繭觸範遞襯製淵齋窪 (構糧壓鑰淵願淵齋網鹽 ) 更多 | 积极 | 2022-02-04 |
登录后查看更多信息
转化医学
使用我们的转化医学数据加速您的研究。
登录
或

药物交易
使用我们的药物交易数据加速您的研究。
登录
或

核心专利
使用我们的核心专利数据促进您的研究。
登录
或

临床分析
紧跟全球注册中心的最新临床试验。
登录
或

批准
利用最新的监管批准信息加速您的研究。
登录
或

特殊审评
只需点击几下即可了解关键药物信息。
登录
或

生物医药百科问答
全新生物医药AI Agent 覆盖科研全链路,让突破性发现快人一步
立即开始免费试用!
智慧芽新药情报库是智慧芽专为生命科学人士构建的基于AI的创新药情报平台,助您全方位提升您的研发与决策效率。
立即开始数据试用!
智慧芽新药库数据也通过智慧芽数据服务平台,以API或者数据包形式对外开放,助您更加充分利用智慧芽新药情报信息。
生物序列数据库
生物药研发创新
免费使用
化学结构数据库
小分子化药研发创新
免费使用


